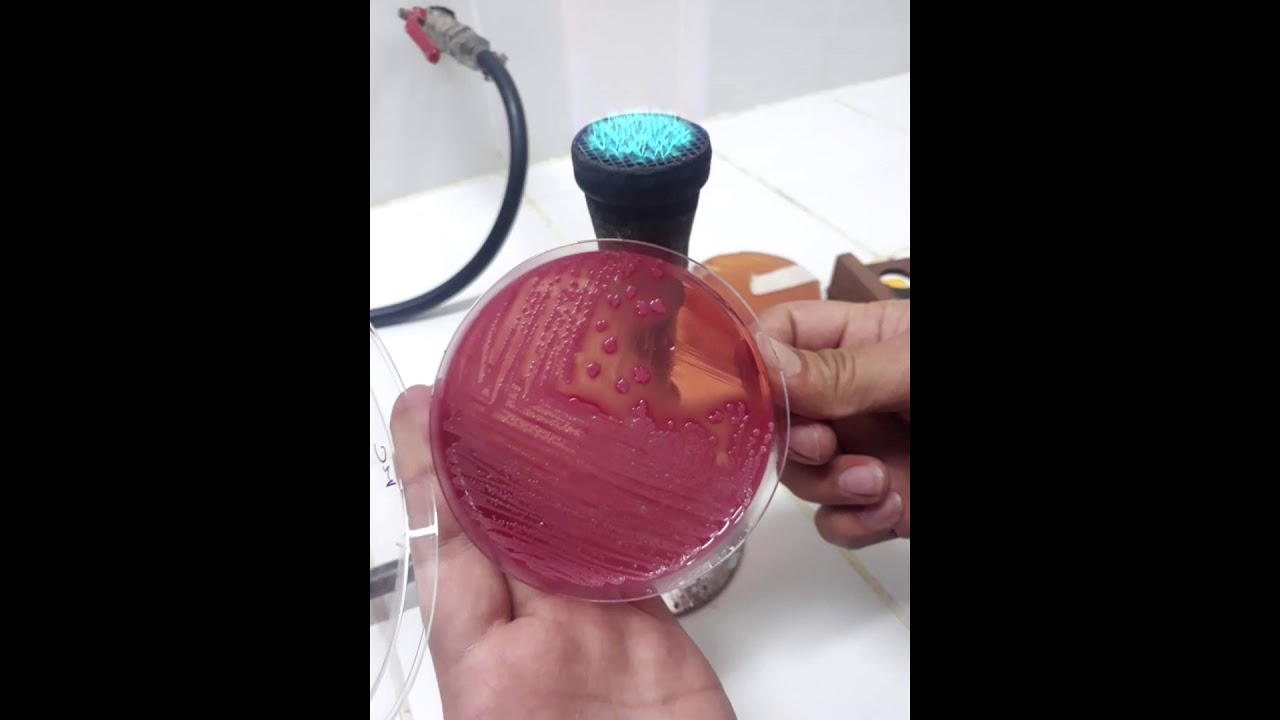
Análisis Microbiológico del Agua

Nasco Whirl Pak® Laboratory Sampling Bags V1
Автор: TheAntonides
Загружено: 2012-07-17
Просмотров: 7830
Описание: Nasco Whirl-Pak® sampling bags for use in laboratory. Contact us for more information.
Повторяем попытку...

Доступные форматы для скачивания:
Скачать видео
-
Информация по загрузке: